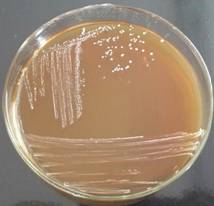

Бромтимоловый агар
Бромтимоловый агар 139 фотографий
Собака лежит на улице
Лучшие концерты ласковый май
Центр качества ставрополь
Пылесос ручной вертикальный рейтинг
Группа винтаж лучшие песни
Хомутово улица колхозная
Devil may cry по порядку
Лучшие гастроэнтерологи омска отзывы
Какой гребной тренажер лучше
Индекс митинской улицы